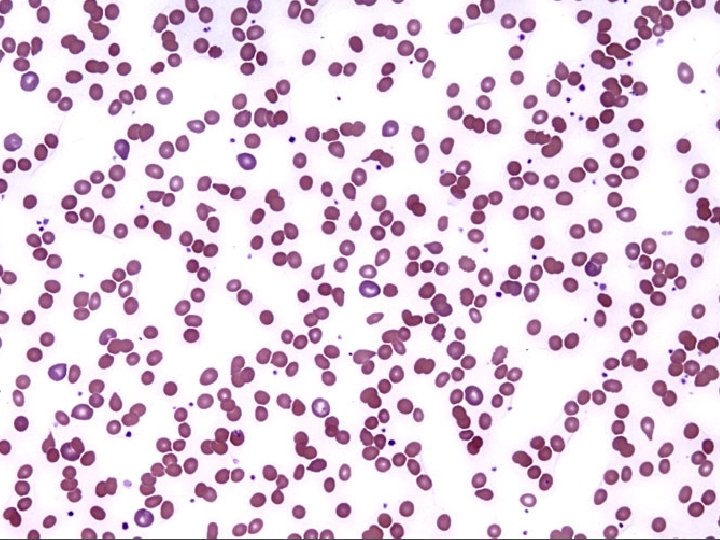

AUTOIMMUNITY AND AUTOIMMUNE DISEASES DISORDERS OF THE IMMUNE

- Slides: 90
AUTOIMMUNITY AND AUTOIMMUNE DISEASES
DISORDERS OF THE IMMUNE SYSTEM * Immunodeficiency • Too little * Hypersensitivity • Too much * Autoimmunity • Misdirected
AUTOIMMUNITY AND AUTOIMMUNE DISEASE * Autoimmunity • Adaptive immune response specific for self-antigens (autoantigens) • Exists due to random generation of TCR and BCR • Represents failures of mechanisms that maintain selftolerance in TCR and BCR * Autoimmune disease • Disease in which the pathology is caused by immune responses to self antigens of normal cells and organs
AUTOIMMUNITY * Paul Ehrlich (1854 – 1915) * In 1906 predicted existence and coined term * Referred to as * Horror autotoxicus * Medical community * Autoimmunity was not possible
AUTOIMMUNE DISEASES * A Group of 60 to 80 chronic inflammatory diseases with genetic predisposition and environmental modulation * Prevalence of 5% to 8% in US * Prevalence is greater for females than males • 75% of cases • 4 th largest disease class in women
RISK FACTORS FOR AUTOIMMUNE DISEASES * Genetic (HLA type) * HLADR 2 with SLE and MS * HLADR 3 with Sjogren’s syndrome, MG, SLE and DM-1 * HLADR 4 with RA and DM-1 * Female * X chromosome inactivation * Environmental * Smoking with RA * Drugs * Procainamide, minocycline, quinidine with DILE * Infections
HLA TYPE AS RISK FACTOR FOR AUTOIMMUNE DISEASES * Model 1 • Certain HLA alleles are better at presenting pathogen peptides which resemble self peptides to T cells * Model 2 • Certain HLA alleles are less efficient at presenting self peptides to developing T cells • Results in failure of negative selection
CLASSIFICATION OF AUTOIMMUNE DISEASES * Organ Specific • • • Insulin dependent diabetes mellitus (IDDM) - Type I Graves’ disease Goodpasture’s syndrome Myasthenia gravis Multiple sclerosis * Systemic • Systemic lupus erythematosus • Rheumatoid arthritis • Sjogren’s syndrome
CLASSIFICATION OF AUTOIMMUNE DISEASES BY EFFECTOR MECHANISMS * Type II • Antibody against cell-surface or extracellular matrix antigens (Type II hypersensitivity) * Type III • Formation and deposition of immune complexes (Type III hypersensitivity) * Type IV • T cell mediated (Type IV hypersensitivity)
TYPE II AUTOIMMUNE DISEASES * Ig. G antibody is primary effector mechanism * Attack more common • Cell surface antigens • Erythrocytes, neutrophils, platelets • Cell surface receptors • TSH, acetylcholine, insulin * Attack less common • Extracellular matrix autoantigens
EFFECTOR MECHANISM OUTCOMES IN TYPE II AUTOIMMUNE DISEASE * Cell surface antigen autoantibodies • Cell and tissue destruction * Cell surface receptor autoantibodies • Agonistic • Stimulate receptor • Antagonistic • Inhibit receptor
AUTOIMMUNE HEMOLYTIC ANEMIA * Destruction of erythrocytes by autoantibodies * Types • Warm (37 C) mediated by Ig. G • Cold (32 C) mediated by Ig. M * Causes of Warm • Idiopathic in 50% of cases • Diseases • Chronic lymphocytic leukemia • Systemic lupus erythematosus • Drugs • Penicillin, methyldopa, quinidine
AUTOIMMUNE HEMOLYTIC ANEMIA * Symptoms • Fatigue, pallor, SOB, tachycardia, jaundice, splenomegaly * Laboratory diagnosis • Coombs’ test • Direct (bound) and Indirect (free) • Elevated reticulocyte count * Treatment • Prednisone • Splenectomy • Immunosuppressive agents
WEGENER’S GRANULOMATOSIS * An uncommon pulmonary-renal disease * Characterized by granulomatous inflammation, necrosis and vasculitis primarily in URT, LRT and kidneys * Pathophysiology • Autoantibodies to proteinase-3 in neutrophil granules • Proteinase-3 translocates to surface following activation of neutrophils * Etiology is unknown and no genetic predispostion * Laboratory diagnosis • Antineutrophil cytoplasmic autoantibodies (ANCA) • Biopsy of lung and kidney
AUTOIMMUNE THROMBOCYTOPENIC PURPURA (ATP) * Synonym * Idiopathic thrombocytopenic purpura (ITP) * Pathophysiology • Ig. G autoantibodies against membrane glycoproteins on surface of thrombocytes (platelets) • Glycoprotein IIb/IIIa complex • Decrease in circulating thrombocytes (thrombocytopenia) • Reference range (150, 000 to 450, 000/u. L) • Clinical significance (< 50, 000/u. L) • Results in hemorrhage
AUTOIMMUNE THROMBOCYTOPENIC PURPURA (ATP) * Clinical forms • Acute in children (2 to 4 years) • Follows infection • Chronic in adults (20 to 50 years) • No specific cause * Risk factors • Diseases • SLE, HIV / AIDS • Drugs • Sulfonamides, ibuprofen, ranitidine, phenytoin, tamoxifen • Laboratory diagnosis • Complete blood count (CBC)
GOODPASTURE'S SYNDROME * An uncommon pulmonary-renal syndrome * Characterized by pulmonary hemorrhage and glomerulonephritis * Pathophysiology • Antibodies to type IV collagen in alveolar and glomerular basement membranes * Laboratory diagnosis • Anti-GBM (Ig. G to glomerular basement membrane) • Biopsy of lung and kidney
ACUTE RHEUMATIC FEVER (ARF) * Non-suppurative sequelae to pharyngitis by Streptococcus pyogenes (Group A Streptococcus / GAS) * 2 to 3 weeks following pharyngitis * Characterized by • Painful polymigratory arthritis • Carditis * Female to male ratio of 1: 1 * Incidence of 0. 5% to 3%
ACUTE RHEUMATIC FEVER (ARF) * Highest incidence/prevalence between 6 and 20 years • Rare >30 years * Effector mechanism • Antibodies to GAS “M” proteins cross reacting to antigens of heart and joints (molecular mimicry) * Associated with rheumatogenic strains • M 1, M 3, M 5, M 6, M 18
ACUTE RHEUMATIC FEVER (ARF) * Radiographic diagnosis • CXR for cardiomegaly * Laboratory diagnosis • Anti-streptolysin-O (ASO) • Reference ranges • 0 to 3 years • 4 to 17 years • Anti-DNase. B • CRP < 250 IL/m. L <400 IL/m. L
GRAVES' DISEASE * Most common cause of hyperthyroidism (thyrotoxicosis) • Incidence of 50 -80 cases / 100, 000 population / year • Female to male ratio of 8: 1 * Effector mechanisms involve auto-reactive antibodies • Thyroid stimulating hormone (TSH) receptor (Thyrotropin receptor) • Thyroid peroxidase / Thyroperoxidase (TPO) • Thyroglobulin • T 3 and T 4
GRAVES' DISEASE * Symptoms • Fatigue, heat intolerance, weight loss, anxiety, restlessness, insomnia, ophthalmopathy * Laboratory diagnosis • Increase in free T 3 (triiodothyronine) and T 4 (thyroxine) serum levels • Decrease in thyroid stimulating hormone (TSH) serum level • Detection of thyroid stimulating hormone (TSH / Thyrotropin) receptor antibody in serum
GRAVES' DISEASE * Risk factors * HLADR 3 * Smoking for ophthalmopathy (5 x) * Treatment • Anti-thyroid drugs • Methimazole (Tapazole) • Radioactive iodine • I-131 • Surgery • Thyroidectomy
HASHIMOTO'S DISEASE (THYROIDITIS) * Alternative names • Chronic lymphocytic thyroiditis • Autoimmune thyroiditis * Female to male ratio of 12: 1 * Effector mechanisms • Autoantibodies specific for • Thyroglobulin • Thyroid peroxidase • CD 8 T cells
HASHIMOTO'S DISEASE (THYROIDITIS) * Most common cause of hypothyroidism in US * Symptoms • Fatigue, cold intolerance, weight gain, depression, enlarged gland * Laboratory diagnosis • T 3, T 4 (decrease) and TSH (increase) serum levels • Autoantibodies to • Thyroid peroxidase (TPO) • Thyroglobulin * Treatment • Replacement therapy (Levothyroxine)
INSULIN RESISTANCE (SYNDROME / DIABETES) * Cells of body display impaired response to effects of insulin * Obesity is most common cause * Precedes Type 2 diabetes * Etiology • Genetic • Mutational events • Acquired • Physical inactivity, medications, diet, aging process
ETIOLOGICAL CATEGORIES OF INSULIN RESISTANCE * Pre-receptor • Abnormal insulin • Antibody to insulin * Receptor • Decreased number of receptors • Mutated receptors • Autoantibody against receptors • Antagonistic • Agonistic * Post-receptor • Defective signal transduction
AUTOIMMUNE INSULIN RECEPTOR DISEASE * Results in either elevated or decreased levels of glucose in blood * Mechanisms • Autoantibodies against insulin receptors on cells * Autoantibodies • Antagonistic • Result in hyperglycemia • Insulin resistant diabetes • Agonistic • Results in hypoglycemia
TYPE III AUTOIMMUNE DISEASES * Directed against autoantigens of many cells of body • Cell surfaces, cytoplasm and nucleus (nucleic acids and nucleoproteins) • Antibody binding initiates inflammatory reactions and soluble immune complexes * Directed against one or two different tissue • Clinical manifestations are systemic
POST-STREPTOCOCCAL ACUTE GLOMERULONEPHRITIS (PSAGN) * Non-suppurative sequelae following pharyngitis and skin infections by Group A Streptococcus (GAS) * 1 to 3 weeks following pharyngitis and skin infections * Characterized by • Edema (peri-orbital) • Hematuria • Hypertension * Male to female ratio of 2: 1
POST-STREPTOCOCCAL ACUTE GLOMERULONEPHRITIS (PSAGN) * Highest incidence/prevalence between 4 to 12 years * Antigens from "Nephritogenic strains“ * M 2, M 12, M 49, M 57, M 59, M 60 * Effector mechanism • Deposition of soluble immune complexes in glomeruli * Laboratory diagnosis • Anti-streptolysin O (ASO) [skin infections show poor response] • Anti-DNase. B • C 3
SYSTEMIC LUPUS ERYTHEMATOSUS (SLE) * Chronic, multi-system inflammatory disease with protean manifestations and remitting course * Clinical manifestations * Musculoskeletal (joint and muscle pain) * Dermatological (malar rash) * Renal (glomerulonephritis) * Female to male ratio of 9: 1 * Etiology is unknown • Genetics, race, hormones, environment
SYSTEMIC LUPUS ERYTHEMATOSUS (SLE) * Effector mechanisms • Autoantibodies to many autoantigens • Most common autoantibody is to ds-DNA • Immune complex deposition on basement membranes with complement activation and inflammation * Laboratory diagnosis • Anti-nuclear antibody (ANA) • IFA (indirect fluorescent antibody) assay using HEp-2 cells • Homogeneous pattern and titer > 1: 160 • Anti ds-DNA • IFA assay using Crithidia lucilliae • C 3 level
TYPE IV AUTOIMMUNE DISEASES * Mediated by T cells • CD 4 TH 1 • CD 8 * Organ specific and systemic AD * It is difficult to identify autoimmune T cells and the autoantigen
INSULIN-DEPENDENT DIABETES MELLITUS (IDDM) * Synonym • Type I diabetes, DM-type I * Accounts for 5% to 10% of diabetes in US * Female to male ratio of 1: 1 * Effector mechanisms • CD 8 T cells and autoantibodies against beta cells • Glutamic acid decarboxylase (GAD) • Insulin
PATHOPHYSIOLOGY OF IDDM * Pancreatic beta cells are damaged by • Infectious agents • Mumps virus, rubella virus, coxsackie B virus • Toxic chemicals * Damaged beta cells present antigens which trigger immune attack in genetically susceptible * Genetic susceptibility • HLA-DQ • HLA-DR 3 • HLA-DR 4
INSULIN-DEPENDENT DIABETES MELLITUS (IDDM) * Symptoms • • • Increased thirst Frequent urination Increased hunger Weight loss Fatigue * Laboratory diagnosis • Random blood glucose (>200 mg/d. L) • Fasting blood glucose (>126 mg/d. L)
RHEUMATOID ARTHRITIS (RA) * Characterized by inflammation of synovial membrane of joints and articular surfaces of cartilage and bone * Vasculitis is a systemic complication * Affects 3% to 5% of U. S. population * Female to male ratio of 3: 1 * HLA DR 4 is genetic risk factor
RHEUMATOID ARTHRITIS (RA) * Effector mechanism • CD 4 T cells, activated B cells, macrophages and plasma cells • 85% of patients have rheumatoid factor * Rheumatoid factor • Ig. M, Ig. G and Ig. A specific for Ig. G • Immune complex formation exacerbates inflammation * Laboratory diagnosis • Rheumatoid factor (RF) • Anti-cyclic citrullinated peptide (Anti-CCP) • C-reactive protein (CRP)
TREATMENT OF RHEUMATOID ARTHRITIS * Fast-acting, first line drugs * Non-steroidal anti-inflammatory drugs (NSAIDs) * Corticosteroids * Analgesic drugs * Slow-acting, second line drugs (Disease-Modifying Antirheumatic Drugs / DMARDs) * * Hydroxychloroquine (Plaquenil) Methotrexate (Rheumatrex) Azathioprine (Imuran) Human monoclonal antibody to TNF-alpha * Infliximab (Remicade) * Adalimumab (Humira) * Etanercept (Enbrel)
MULTIPLE SCLEROSIS (MS) * Chronic unpredictable disease of CNS with four possible clinical courses * Characterized by patches of demyelination and inflammation of myelin sheath * Prevalence higher in Northern Hemisphere • North of 37 th parallel (125 cases /100, 000) • South of 37 th parallel (70 cases /100, 000) * Female to male ratio of 2: 1
MULTIPLE SCLEROSIS (MS) * Effector mechanisms • Myelin basic protein is primary autoantigen for CD 4 TH 1 cells * Radiology diagnosis • MRI for detecting demyelinating lesions (plaques) • Laboratory diagnosis • High resolution protein electrophoresis for • Oligoclonal bands in CSF